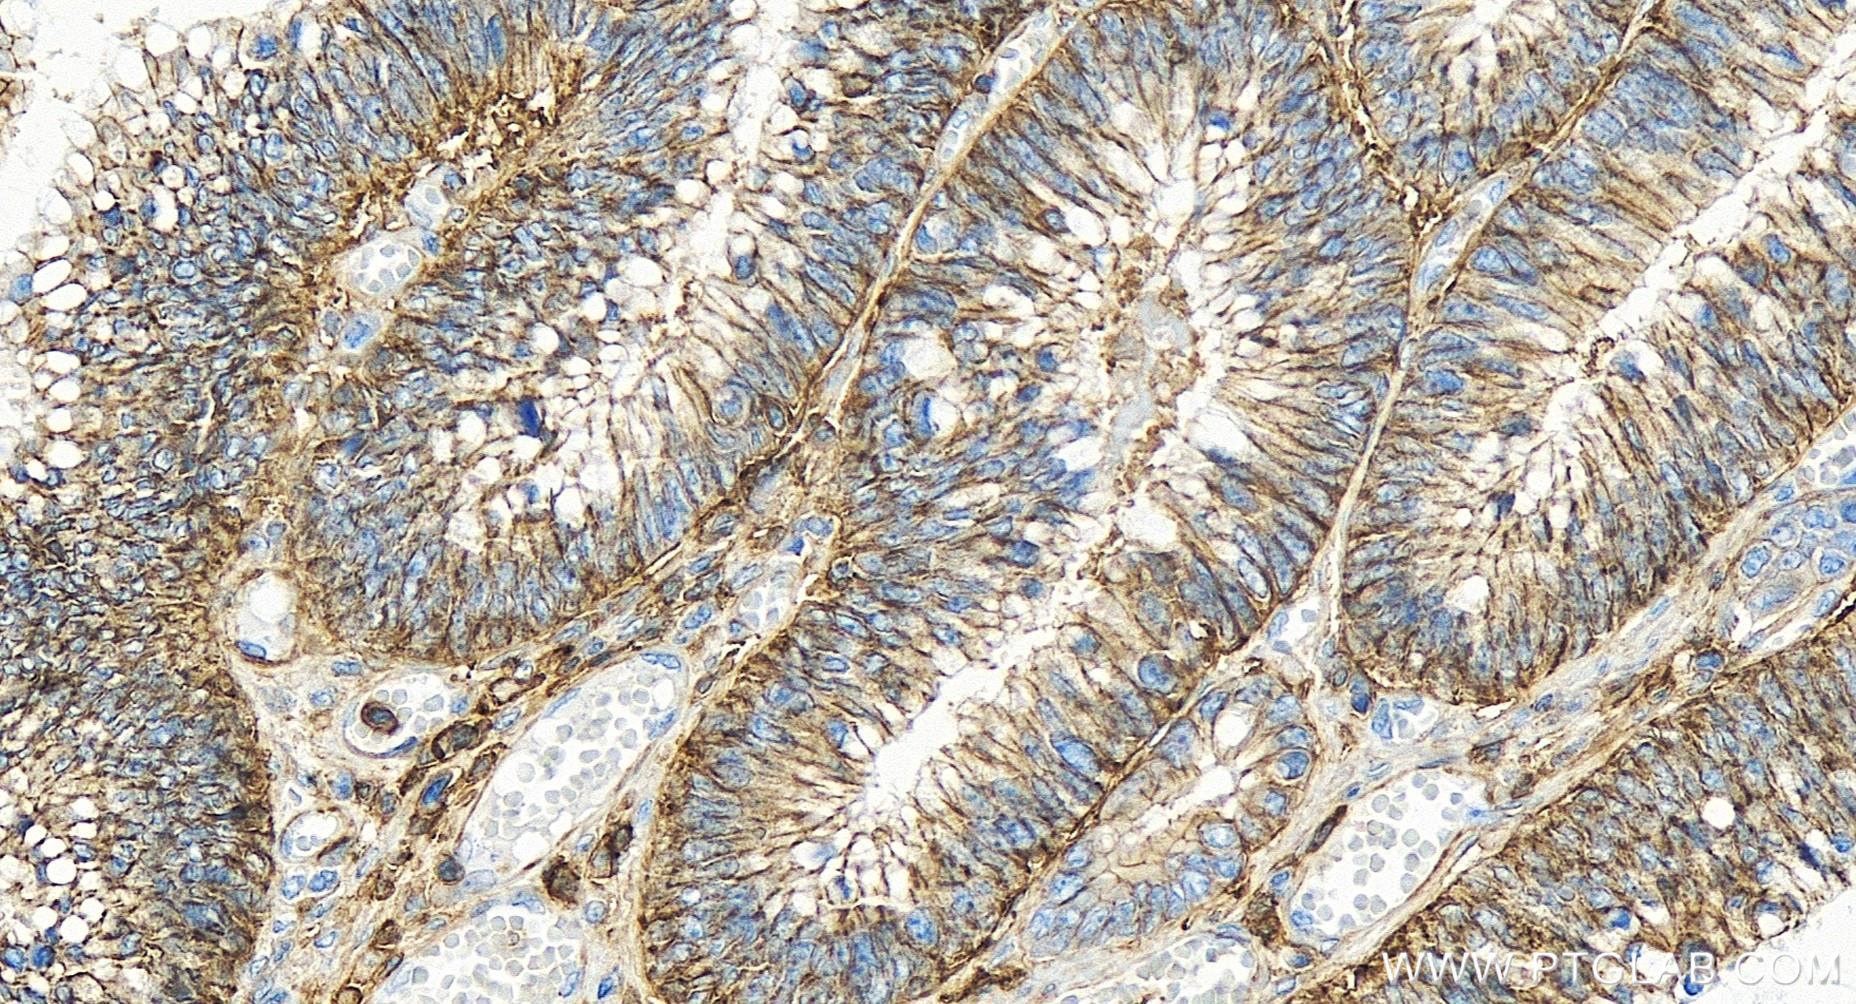

验证数据展示
产品信息
84854-5-PBS targets CD44 in WB, IHC, IF/ICC, Indirect ELISA applications and shows reactivity with human samples.
| 经测试应用 | WB, IHC, IF/ICC, Indirect ELISA Application Description |
| 经测试反应性 | human |
| 免疫原 |
CatNo: Eg1057 Product name: Recombinant Human CD44 protein (His Tag) Source: mammalian cells-derived, pHZ-KIsec-C-6*HIS Tag: C-6*HIS Domain: 21-649 aa of NM_000610.3 Sequence: QIDLNITCRFAGVFHVEKNGRYSISRTEAADLCKAFNSTLPTMAQMEKALSIGFETCRYGFIEGHVVIPRIHPNSICAANNTGVYILTSNTSQYDTYCFNASAPPEEDCTSVTDLPNAFDGPITITIVNRDGTRYVQKGEYRTNPEDIYPSNPTDDDVSSGSSSERSSTSGGYIFYTFSTVHPIPDEDSPWITDSTDRIPATTLMSTSATATETATKRQETWDWFSWLFLPSESKNHLHTTTQMAGTSSNTISAGWEPNEENEDERDRHLSFSGSGIDDDEDFISSTISTTPRAFDHTKQNQDWTQWNPSHSNPEVLLQTTTRMTDVDRNGTTAYEGNWNPEAHPPLIHHEHHEEEETPHSTSTIQATPSSTTEETATQKEQWFGNRWHEGYRQTPKEDSHSTTGTAAASAHTSHPMQGRTTPSPEDSSWTDFFNPISHPMGRGHQAGRRMDMDSSHSITLQPTANPNTGLVEDLDRTGPLSMTTQQSNSQSFSTSHEGLEEDKDHPTTSTLTSSNRNDVTGGRRDPNHSEGSTTLLEGYTSHYPHTKESRTFIPVTSAKTGSFGVTAVTVGDSNSNVNRSLSGDQDTFHPSGGSHTTHGSESDGHSHGSQEGGANTTSGPIRTPQIPE 种属同源性预测 |
| 宿主/亚型 | Rabbit / IgG |
| 抗体类别 | Recombinant |
| 产品类型 | Antibody |
| 全称 | CD44 molecule (Indian blood group) |
| 别名 | 242345G11, CD44 antigen, CDW44, CSPG8, ECMR III |
| 计算分子量 | 82 kDa |
| 观测分子量 | 80-95 kDa |
| GenBank蛋白编号 | NM_000610.3 |
| 基因名称 | CD44 |
| Gene ID (NCBI) | 960 |
| ENSEMBL Gene ID | ENSG00000026508 |
| 偶联类型 | Unconjugated |
| 形式 | Liquid |
| 纯化方式 | Protein A purfication |
| UNIPROT ID | P16070-1 |
| 储存缓冲液 | PBS only, pH 7.3. |
| 储存条件 | Store at -80°C. The product is shipped with ice packs. Upon receipt, store it immediately at -80°C |
背景介绍
CD44 is a type I transmembrane glycoprotein expressed on embryonic stem cells and in various levels on other cell types including connective tissues and bone marrow. CD44 expression is also upregulated in subpopulations of cancer cells and is recognized as a molecular marker for cancer stem cells (PMID: 29747682). It is a cell-surface receptor that mediates cell-cell and cell-matrix interactions through its affinity for hyaluronic acid (HA) and possibly also through its affinity for other ligands (PMID: 10694938). Adhesion with HA plays an important role in cell migration, tumor growth and progression. CD44 is also involved in lymphocyte activation, recirculation and homing, and in hematopoiesis.